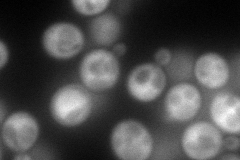
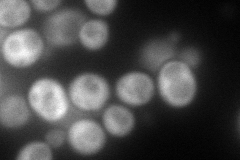
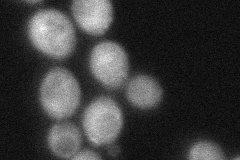

View description
Regulatory subunit of trehalose-6-phosphate synthase/phosphatase complex, which synthesizes the storage carbohydrate trehalose; expression is induced by stress conditions and repressed by the Ras-cAMP pathway
Localization:
Intensity:
Fold change:
Significance:
-
C’ GFP library in SD

cytosol74.56 -
N' NOP1pr-GFP in SD
cytosol157.821 -
N' TEF2pr-mCherry in SD
cytosol148.292 -
N' NATIVEpr-GFP in SD

cytosol26.4937 -
N' TEF2pr-VC and Cyto-VN in SD
cytosol50.6633 -
C’ GFP library in SD+DTT

cytosolN/AN/ANo -
C’ GFP library in SD+H2O2

cytosol91.071.22No -
C’ GFP library in Starvation Media

cytosol95.381.27No -
C’ GFP library on the background of Pup2-DaMP

cytosol -
C’ GFP library on the background of CCT mutant

cytosol94.48331.26718No
